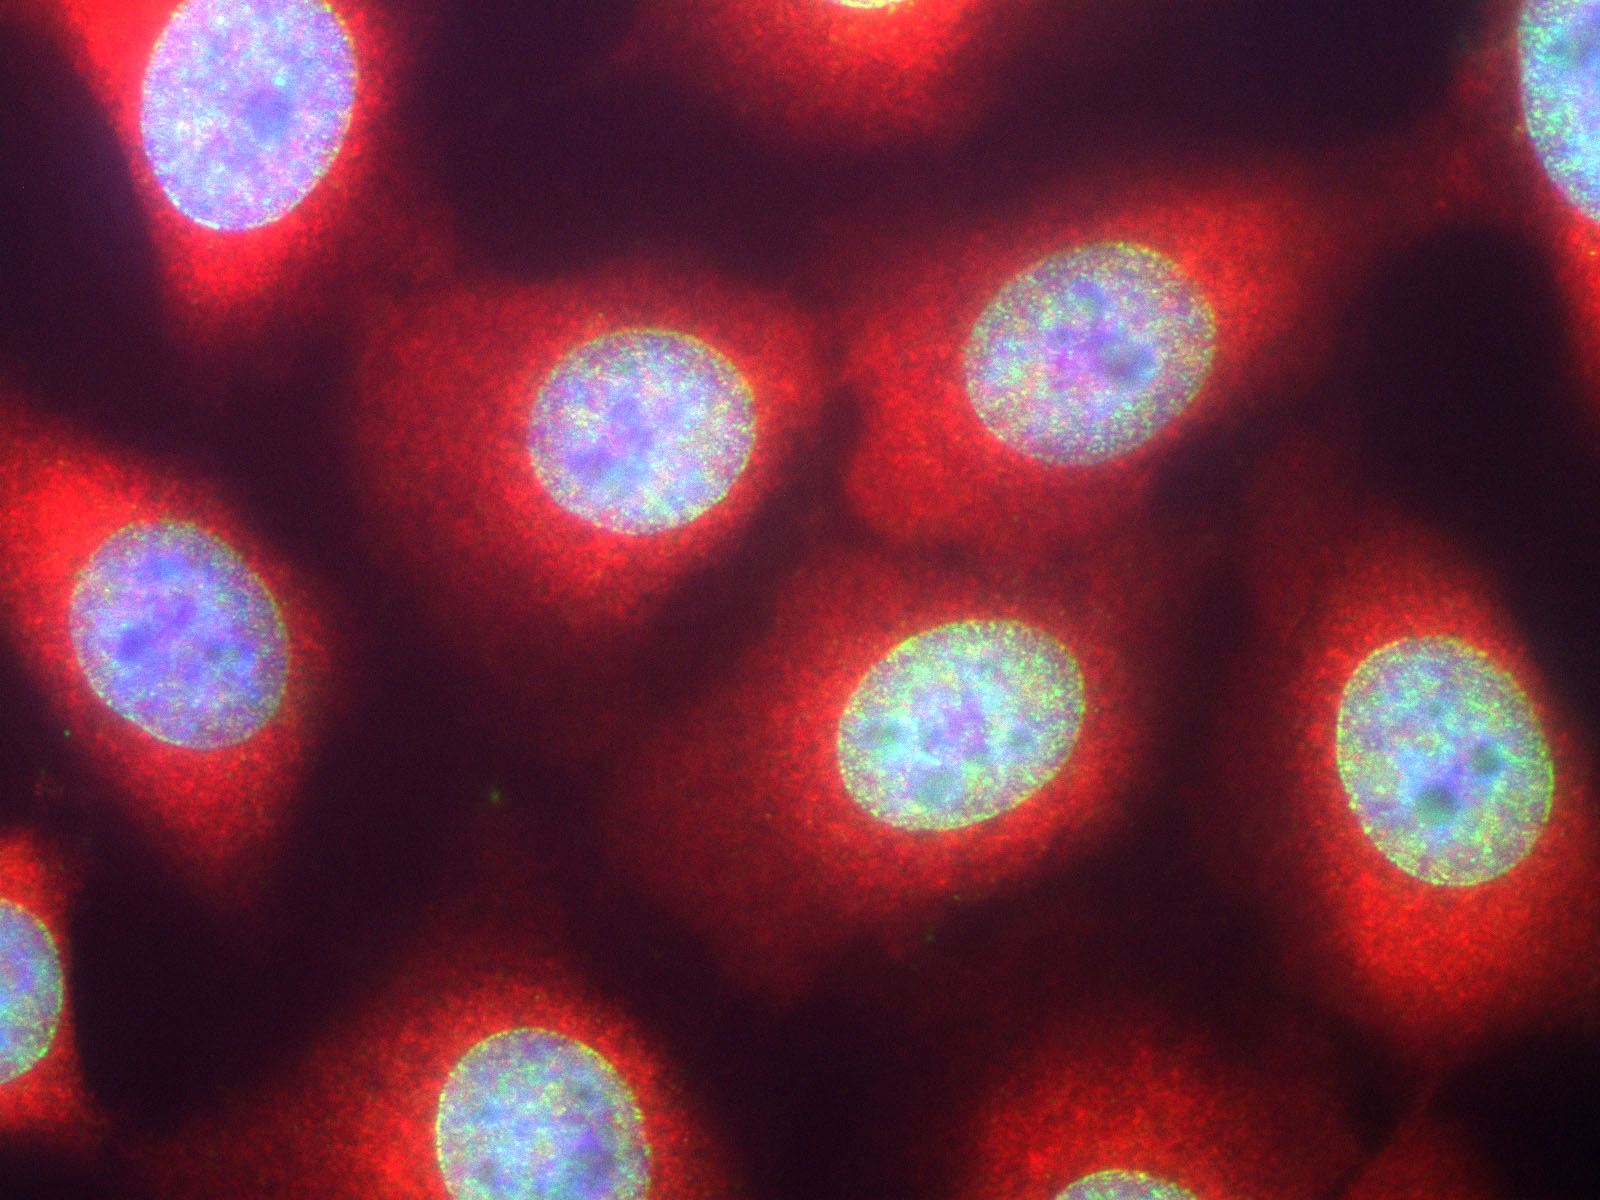

Polyclonal Antibody to Casein Kinase 1 Alpha(Discontinued)
Figure 1: High power image of HeLa cells stained with chicken casein kinase 1 alpha antibody (red) and our panspecific mouse monoclonal antibody to nuclear pore complexes 34-1096 (green). Casein kinase 1 alpha has a particulate distribution both in the nucleus and the cytoplasm. Blue is the Hoechst DNA stain. High quality immunocytochemical images made using this antibody are shown in reference 4.
Roll over image to zoom in
Shipping Info:
For estimated delivery dates, please contact us at [email protected]
| Format : | Conc. IgY prep. |
| Amount : | 100 µl |
| Isotype : | Chicken, IgY |
| Content : | Antibody is supplied as an aliquot of concentrated IgY preparation. |
| Storage condition : | Store the antibody at 4°C; stable for 6 months. For long-term storage; store at -20°C. Avoid repeated freeze and thaw cycles. |
Western blot: 1:10,000 IF: 1:500-1:1000 ABC: 1:5,000
For Research Use Only. Not for use in diagnostic/therapeutics procedures.
| Subcellular location: | Cytoplasm, Cytoplasm, Chromosome, Nucleus speckle, Cytoplasm |
| BioGrid: | 107836. 221 interactions. |
|
There are currently no product reviews
|

.png)












